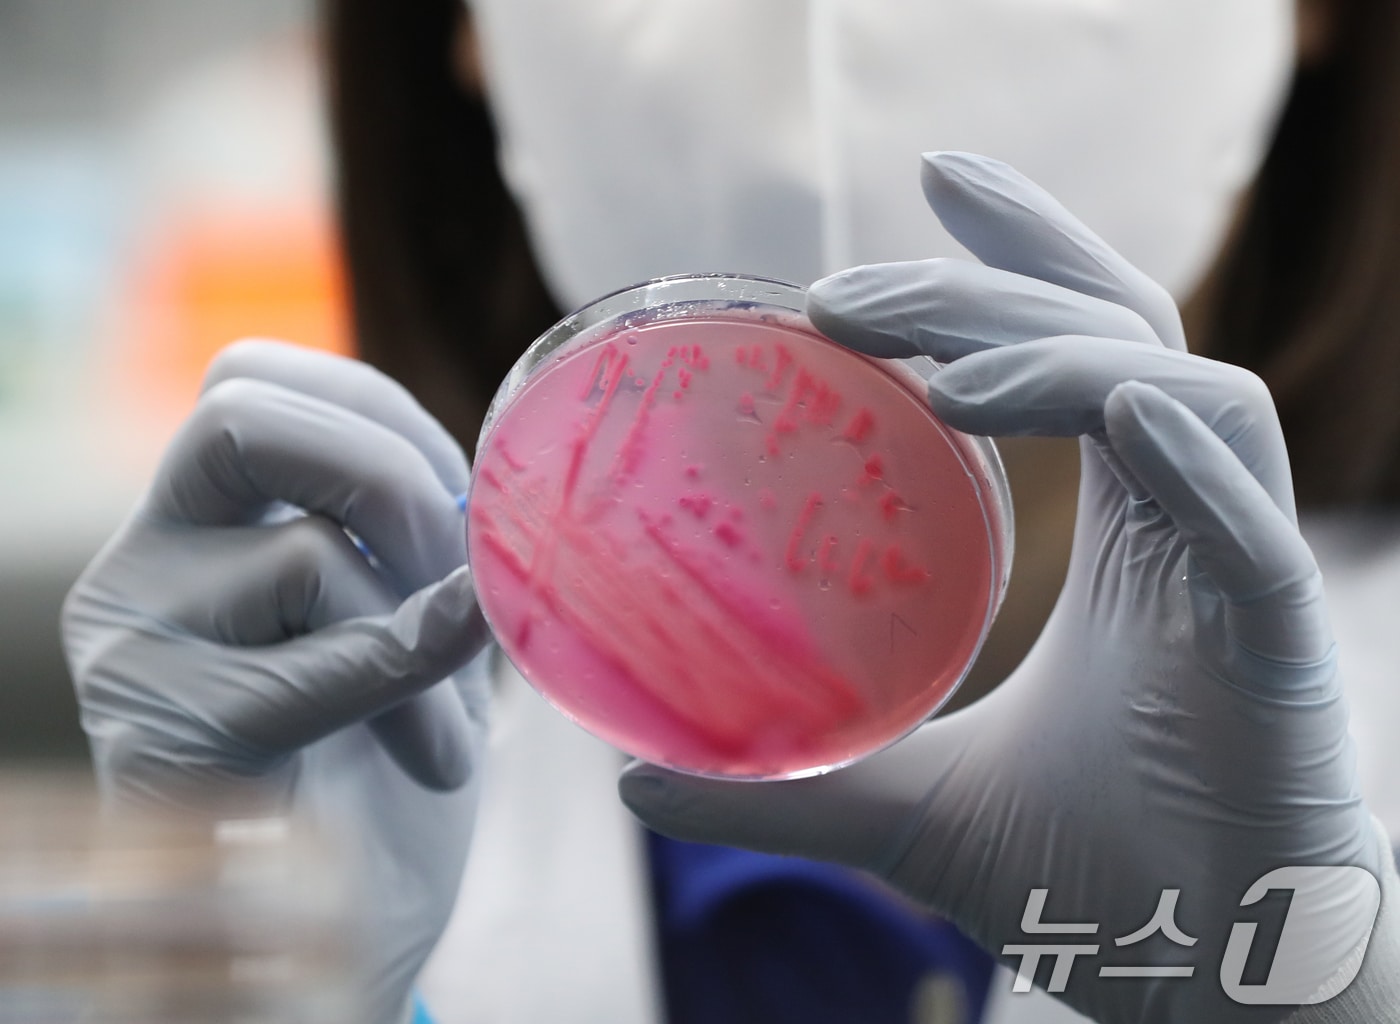
대구시는 올 여름 식중독 예방을 위해 오는 20일까지 유관기관 합동점검을 실시한다. 사진은 식중독균 배양검사를 하는 모습. 뉴스1 ⓒ News1 자료 사진

여름철 식중독 비상…대구시, 20일까지 사회복지 급식시설 207곳 점검
- 남승렬 기자
(대구=뉴스1) 남승렬 기자 = 무더위가 기승을 부리는 본격적인 여름철을 맞아 식중독 예방에 비상이 걸렸다.
11일 보건 당국에 따르면 식중독은 폭염이 시작되는 여름철에 빈번히 발생한다. 음식물을 섭취할 때 소화기가 감염돼 설사, 복통 등의 증상이 급성 또는 만성으로 나타나는 질환이다.
식중독은 개인위생 수칙 준수와 사전 점검을 통해 예방이 가능하다.
이에 따라 대구시는 올여름 식중독 예방을 위해 20일까지 유관기관 합동점검을 실시할 방침이다.
구·군 및 대구시 소비자식품위생감시원 등 민·관 합동점검반을 구성해 집단급식소 및 50인 미만 급식시설 207곳을 점검할 계획이다.
주요 점검 내용은 소비기한 경과 제품 사용 여부, 부패·변질 및 무표시 원료 사용 여부, 비위생적 식품 취급 여부, 조리 종사자 건강진단 이행 여부, 급식시설 및 기구 세척 소독 관리 여부 등이다.
대구시는 급식 다빈도 제공 식품, 조리 음식 및 식중독 발생 우려가 높은 식재료 등에 대해서는 수거검사를 병행해 급식환경뿐만 아니라 식재료에 대해 점검도 할 예정이다.
또 소비기한 경과 제품 보관 등 위반 사항이 적발될 경우 관련 법규에 따라 행정처분을 진행할 예정이다.
대구시 관계자는 "기온이 오르며 식중독 위험이 높아지는 여름철 사회복지 급식시설 안전관리를 철저히 하는 등 집단 식중독 예방 활동에 힘을 쏟겠다"고 말했다.
pdnamsy@news1.kr
Copyright ⓒ 뉴스1. All rights reserved. 무단 전재 및 재배포, AI학습 이용금지.









